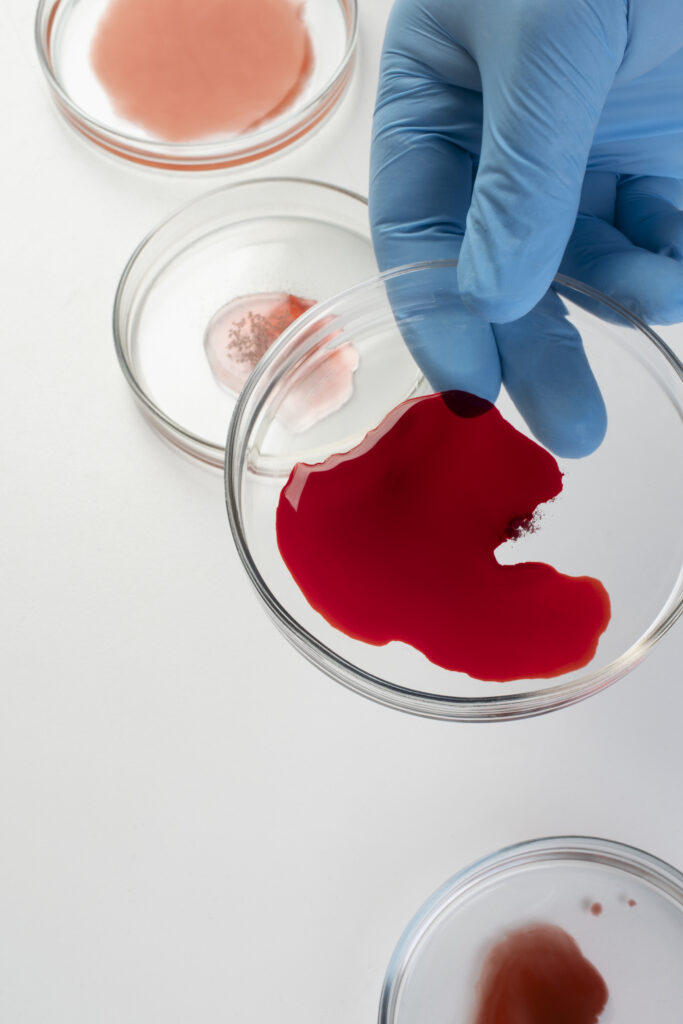

Test krvi za otkrivanje raka: Revolucionarni pristup ranoj dijagnozi karcinoma
Prema najnovijim istraživanjima, svetska medicina stoji na pragu revolucionarnog pomaka u ranoj dijagnostici karcinoma. Novi test krvi koji se trenutno testira u Velikoj Britaniji pokazao je impresivne rezultate u otkrivanju širokog spektra karcinoma, od kojih tri četvrtine nemaju nikakav oblik programa skrininga. Ova tehnologija, poznata kao test Galeri, proizvedena od strane američke farmaceutske kuće “Gral”, predstavlja potencijalno prekretnicu u borbi protiv raka.
Test krvi za otkrivanje raka: Kako funkcioniše test Galeri
Test Galeri koristi naprednu tehnologiju koja detektuje fragmente kancerogene DNK koji su se odvojili od tumora i cirkulišu u krvi. Ova metoda, poznata kao analiza cirkulišuće tumorske DNK (ctDNA), omogućava neinvazivno otkrivanje raka u ranim fazama kada je lečenje najefikasnije. Tehnologija se zasniva na sposobnosti da identifikuje specifične genetske promene karakteristične za različite vrste karcinoma, što omogućava ne samo detekciju prisustva bolesti već i određivanje njene lokacije u organizmu.
Princip rada testa podrazumeva analizu krvnog uzorka pacijenta u potrazi za DNK fragmentima koji nose tumorske mutacije. Ovi fragmenti, iako prisutni u veoma malim količinama, nose jedinstven genetski potpis koji ih razlikuje od normalne DNK. Napredni algoritmi mašinskog učenja analiziraju ove podatke kako bi identifikovali prisustvo karcinoma i odredili njegovo poreklo sa impresivnom tačnošću.
Test krvi za otkrivanje raka: Rezultati studije u Severnoj Americi
U studiji koja je pratila 25.000 odraslih iz SAD i Kanade tokom godinu dana, test je pokazao izuzetne rezultate. Skoro jedan od 100 ispitanika dobio je pozitivan rezultat, a u 62% ovih slučajeva, rak je kasnije potvrđen dodatnim dijagnostičkim procedurama. Ovi podaci ukazuju na visoku specifičnost testa, što je ključno za njegovu praktičnu primenu u kliničkoj praksi.
| Parametar | Vrednost |
|---|---|
| Broj ispitanika | 25.000 |
| Pozitivni rezultati | 1 od 100 |
| Potvrđeni slučajevi raka | 62% |
| Tačnost isključivanja raka | preko 99% |
| Rani stadijumi otkriveni | preko 50% |
Posebno impresivno je da je test ispravno isključio rak kod preko 99% onih koji su imali negativan rezultat, što značajno smanjuje rizik od nepotrebnih dodatnih pregleda i anksioznosti pacijenata. Više od polovine otkrivenih karcinoma bilo je u ranoj fazi, gde su šanse za uspešno lečenje ili čak izlečenje najveće.
Test krvi za otkrivanje raka: Doprinos postojećim programima skrininga
Kada se kombinuje sa tradicionalnim programima skrininga za rak dojke, creva i grlića materice, test Galeri je povećao broj otkrivenih karcinoma ukupno sedam puta. Ova sinergija predstavlja ogroman napredak u preventivnoj medicini, jer omogućava otkrivanje vrsta raka koje do sada nisu bile obuhvaćene redovnim pregledima.
Ključno je da su tri četvrtine otkrivenih karcinoma bili oni koji nemaju program skrininga, kao što su rak jajnika, jetre, želuca, bešike i pankreasa. Ovi karcinomi su često otkriveni u naprednim fazama kada su opcije lečenja ograničene, što ovaj test čini posebno važnim za poboljšanje preživljavanja pacijenata sa ovim vrstama tumora.
Test krvi je ispravno identifikovao poreklo raka u devet od deset slučajeva, što je kritično za brzo usmeravanje pacijenata na odgovarajuće specijaliste i početak adekvatne terapije. Ova sposobnost lokalizacije tumora predstavlja dodatnu vrednost u odnosu na druge metode skrininga koje samo ukazuju na prisustvo bolesti.
Test krvi za otkrivanje raka: Tehnološki aspekti i naučna osnova
Tehnologija koja stoji iza testa Galeri predstavlja vrhunac decenija istraživanja u oblasti molekularne biologije i genomske medicine. Metoda sekvenciranja nove generacije omogućava analizu miliona DNK fragmenta iz samo jednog uzorka krvi, identifikujući one koji nose tumorske karakteristike. Ova tehnologija se kontinuirano usavršava, sa ciljem da postane još senzitivnija i specifičnija.
Jedan od ključnih izazova u razvoju ovakvih testova je razlikovanje benignih od malignih promena, kao i identifikacija klinički značajnih tumora od onih koji možda nikada neće uzrokovati probleme pacijentu. Napredni algoritmi koji se koriste u testu Galeri dizajnirani su da minimiziraju lažno pozitivne rezultate i maksimiziraju detekciju agresivnih tumora koji zahtevaju hitnu intervenciju.
Ova tehnologija se kontinuirano razvija, sa fokusom na poboljšanje senzitivnosti za rane faze raka, gde su količine cirkulišuće tumorske DNK najmanje. Buduća istraživanja će se verovatno usmeriti na kombinovanje različitih biomarkera kako bi se dodatno poboljšala tačnost testa.
Klinička primena i implementacija
Trenutno, test Galeri se testira u okviru Nacionalne zdravstvene službe Velike Britanije, što predstavlja važan korak ka njegovoj široj kliničkoj primeni. Troogodišnje ispitivanje koje obuhvata 140.000 pacijenata NHS-a u Engleskoj će pružiti kĺjučne podatke o efikasnosti testa u stvarnim uslovima i njegovom uticaju na ishode lečenja.
Implementacija ovakvog testa u redovnu zdravstvenu praksu zahteva pažljivo planiranje i razvoj odgovarajućih protokola. Kliničari će morati da se obuče za tumačenje rezultata testa i donošenje odluka na osnovu njih, posebno u slučajevima graničnih vrednosti ili neodređenih rezultata. Takođe je neophodno razviti jasne smernice za dalje dijagnostičke procedure kod pacijenata sa pozitivnim rezultatima.
Ekonomski aspekti implementacije ovakvog testa takođe su važni za razmatranje. Iako početni troškovi mogu biti visoki, potencijalna ušteda od lečenja naprednih stadijuma raka i poboljšanje kvaliteta života pacijenata mogu opravdati investiciju. Studije troškovne efikasnosti će biti kĺjučne za donošenje odluka o uvodenju testa u nacionalne programe zdravstvenog osiguranja.
Etički i društveni aspekti
Uvođenje novih tehnologija za skrining raka nosi sa sobom brojne etičke izazove. Jedan od glavnih je pitanje prekomernog dijagnostikovanja – otkrivanje karcinoma koji možda nikada ne bi uzrokovali probleme pacijentu. Kao što je istakao Naser Turabi iz organizacije Cancer Research UK, potrebna su dalja istraživanja kako bi se “izbeglo prekomerno dijagnostikovanje karcinoma koji možda nisu proizrokovali štetu”.
Psihološki uticaj na pacijente je još jedan važan aspekt. Pozitivni rezultati testa mogu izazvati značajnu anksioznost, posebno dok se ne potvrdi dijagnoza dodatnim testovima. Stoga je neophodno razviti odgovarajuće savetodavne službe i podršku za pacijente koji prolaze kroz ovaj proces.
Pristup testu i pitanja jednakosti takođe su važni za razmatranje. Kako bi se osiguralo da svi koji mogu imati koristi od testa budu u mogućnosti da ga koriste, neophodno je razmotriti načine finansiranja i dostupnost u različitim regionima i socioekonomskim grupama.
Budućnost testova krvi za rak
Rezultati testa Galeri predstavljaju samo početak razvoja tehnologija za rano otkrivanje raka putem analize krvi. Naučnici već rade na sledećoj generaciji testova koji će biti još senzitivniji i specifičniji, sa mogućnošću detekcije još ranijih faza bolesti.
Budući pravci istraživanja uključuju kombinovanje analize cirkulišuće tumorske DNK sa drugim biomarkerima, kao što su proteinski markeri ili analiza cirkulišućih tumorskih ćelija. Ovakav multiomni pristup može značajno poboljšati tačnost dijagnoze i omogućiti personalizovaniji pristup lečenju.
Razvoj testova za specifične populacije sa povećanim rizikom od određenih vrsta raka takođe predstavlja važan pravac istraživanja. Ovi testovi bi mogli da se koriste za praćenje pacijenata sa poznatim genetskim predispozicijama ili drugim faktorima rizika, omogućavajući još raniju intervenciju.
Globalni uticaj i perspektive
Potencijalni uticaj testova krvi za otkrivanje raka na globalnom nivou je ogroman. U zemljama u razvoju gde tradicionalni programi skrininga možda nisu široko dostupni, ovi testovi bi mogli da obezbede pristupačniju alternativu za rano otkrivanje bolesti. Jednostavnost uzorkovanja i mogućnost transporta uzoraka do centralizovanih laboratorija čini ovu tehnologiju posebno pogodnom za primenu u resursima ograničenim sredinama.
Kako tehnologija napreduje i troškovi proizvodnje opadaju, moguće je da će testovi krvi za rak postati deo rutinskih preventivnih pregleda širom sveta. Ovo bi moglo da dovede do značajnog smanjenja smrtnosti od raka i poboljšanja kvaliteta života miliona ljudi.
Medicinska zajednica sa nestrpljenjem očekuje rezultate većih studija koje će pružiti konačne dokaze o efikasnosti ovih testova u smanjenju smrtnosti od raka. Kao što je istaknula dr Kler Ternbul, profesorica translacione genetike raka na Institutu za istraživanje raka u Londonu, “podaci iz randomizovanih studija, sa smrtnošću kao krajnjom tačkom, biće apsolutno neophodni da bi se utvrdilo da li naizgled ranije otkrivanje od strane Galerija dovodi do koristi u smrtnosti”.